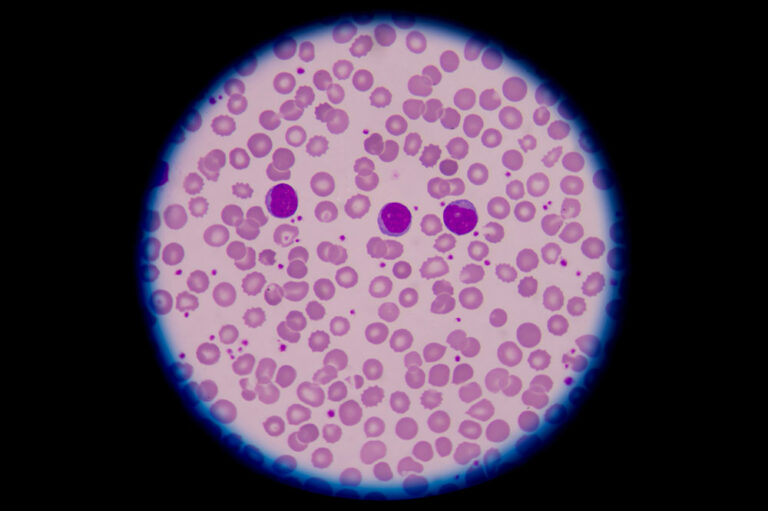
Everything you need to know about blood disorders

health
Eat these 6 foods to keep anemia at bay
The blood mainly comprises three types of cells: White Blood Cells (WBCs) that stave off infections and diseases, platelets that help heal wounds, and Red Blood Cells (RBCs) that carry oxygen throughout the body. A depletion in RBCs due to lack of nutrition or an underlying disease leads to anemia and manifests symptoms that can range from persistent fatigue to irregular heartbeats. There are several types of anemia categorized on the basis of the causes and symptoms. Several health experts suggest that, apart from early diagnosis and timely treatment, following a healthy diet and ensuring proper nutrition are key to maintaining healthy levels of RBCs in the body. Here are a few power-packed foods that can help keep the symptoms of anemia at bay: Dark leafy greens The deficiency of iron has long been synonymous with anemia. So, don’t forget to add leafy greens like spinach and kale into your basket the next time you’re out buying vegetables. Also, you must up your intake of leafy green veggies if you depend only on plant sources of iron, as the body absorbs less of the nutrient. Lean meats If you’re looking for a larger dose of iron and don’t mind meat on your plate, grass-fed lean meat is a perfect source.
Read More